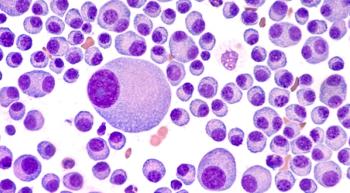

Myeloma
Latest News
Latest Videos

More News

Financial burdens from medical costs negatively affect quality of life in patients who have received stem cell transplants, recent research showed.

The novel drug, IDP-023, is being investigated in patients with relapsed or refractory non-Hodgkin lymphoma or multiple myeloma.

A treatment combination of Sarclisa, Kyprolis, Revlimid and dexamethasone demonstrated a complete response in patients who were newly diagnosed with multiple myeloma.

Study findings support the use of a financial navigation program, in hopes of aiding patients with multiple myeloma affected by financial toxicity.

A novel cell therapy demonstrated early efficacy and an acceptable safety profile in patients with graft-versus-host disease undergoing haploidentical stem cell transplantation.

The quality-of-life improvement with Abecma in patients with relapsed/refractory multiple myeloma was greater when compared with standard regimens.

Research demonstrated comparable outcomes in the real-world setting and in the phase 2 MajesTEC-1 trial when it came to treatment with Tecvayli for relapsed or refractory myeloma.

From FDA concerns to a potential new drug, CAR-T cell therapies were dominating oncology headlines last week.

I didn't know that a side effect of bone strengtheners could be jawbone detachment.

An expert discusses the FDA’s investigation into the possible association between CAR-T cell therapy and secondary T-cell malignancies.

The FDA announced rare instances of secondary diseases or cancers from CAR-T cell therapy, though this is not the first time that oncology treatments have been associated with secondary diseases.


I found family in my cancer support groups.

From actor Patrick Dempsey saying that his late mother would be proud of his work at The Dempsey Center to a “General Hospital” actor discussing his cancer treatments, here’s what’s happening in the oncology space this week.

Findings from a phase 2 trial showed improvements in relapse-free survival with an mRNA vaccine plus Keytruda compared with Keytruda alone in patients with high-risk resected melanoma.

Researchers have found that, among patients with relapsed/refractory multiple myeloma who received treatment with the CAR-T cell therapy Abecma, race and ethnicity played roles in safety and response but not survival.

Braving the storm that is cancer.

Patients with cancer and diabetes need to carefully co-manage both diseases, as one expert tells CURE.

A new phase 1 trial is testing their first patients with STAR-LLD in the treatment of patients with multiple myeloma.

A new T-cell therapy showed benefits in patients with relapsed/refractory multiple myeloma.

Patients receiving Tecvayli for relapsed/refractory multiple myeloma had similar efficacy results and side effects, compared with another trial.

A low rate of high-grade blood-related side effects following treatment with induction Dara-KRd and consolidation double transplant was discovered in a trial for patients with high-risk, newly diagnosed multiple myeloma.
Pomalyst plus Velcade with dexamethasone improves survival outcomes for patients with relapsed/refractory multiple myeloma, according to a phase 3 trial.

An expert sat down with CURE® and discussed how stem cells are collected before a patient with myeloma undergoes a stem cell transplant.

Patients with multiple myeloma who are undergoing systemic treatment can see improvements from exercise, a recent study shows.